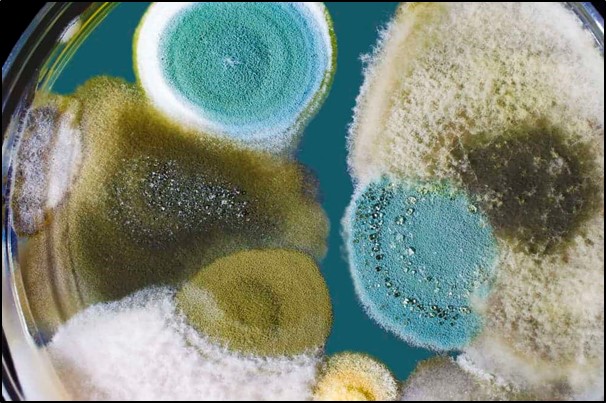

Our 30 Detox Pathways
Today's reality is that we live in a very toxic world!
Generally, most people associate detoxes to the physical body alone. But we teach people to detox both the MIND, the BODY and the SPIRIT. Only then can we fully heal holistically!
Between the glyphosates, the pesticides, chemicals, sprays and geo-engineered and/or modified foods, the compromised contaminated drinking water, not to mention the scores of heavy metals in both the vaccines and the chemtrails being sprayed down upon us, plus of course the dirty electricity, from electro-magnetic radiation right up to the damaging 5G signals/radiation, we must make detoxing the BODY a significant part of our daily lifestyle.


























Then we have the Swiss Bionic PEMF Therapy Mat which employs Pulsed Electro Magnetic Field therapy, chromotherapy (colour), brain entrainment, solfeggio frequencies and far-infra-red built into the solid copper coil applicator. It is an amazing treatment for recharging the body, stimulating cell metabolism and thus assisting the detox processes through improved flow.
At our Berry Wellness Centre we provide several modalities for our clients. Our entire philosophy around wellness acknowledges the simple fact that everything is energy, frequency and vibration. That's why we teach in our seminars about the benefits of colour, sound and resonance, especially in regards to the detox benefits of tailored frequency protocols. At our Berry Wellness Centre we provide several modalities for our clients.
Our primary technology is the Rife Spooky2 Central unit, utilizing Plasma, Phanotron, Cold Laser, PEMF, Contact/Tens Pads, Remote (via Quantum Entanglement) and Bio-feedback. This machine enables very advanced detox protocols to be run via multiple modes for minutes, hours, even days on end.
Once you start to fully acknowledge that you are a divine light being, then you can begin to appreciate the relationship that resonant frequencies, including sound vibrations and colour resonance have on your wellness.
Once you start to obverse how these healing modalities impact us on all three levels - the MIND, the BODY and the SPIRIT, you realize that this is all you need to take control of your health and well-being. You also begin to understand the damaging effect synthetic alternatives have on us vibrationally.
If you aren't already taking advantage of the ancient solfeggio frequencies by incorporating them into your daily wellness regime, then you need to begin straight away. The summary benefits are as follows:-
174hz - physical pain relief and stress release
285hz - tissue restoration and healing
396hz - guilt and fear diminishment
417hz - trauma healing
432hz - whole body healing
528hz - relaxation and sleep improvement
639hz - improvement in mental balance
741hz - detoxification of the mind and body
852hz - nervousness and anxiety relief
963hz - increased positive energy and clarity
Add to these the healing benefits of colour/light, in particular those corresponding to the chakras/energy centres of the body, with the specific wavelengths activating energy in the corresponding chakra.
It makes sense that healing comes from energy, frequency and vibration given that we are energy, frequency and vibration, as is the entire cosmos.
#2 Detox - Electrolyzed Reduced Water
Given the symbiotic relationship between the SUN, our BLOOD, and the STRUCTURED EZ WATER found intra-cellularly within the human body, our education seminars focus on teaching people that their current relationship with water is a direct reflection of their health and wellness.
Often we meet people who think they have a healthy relationship with water, until they learn that the quality of what they have been drinking is nowhere near what they were led to believe.
Based on the entire philosophy of the terrain paradigm, and given that we are 75%+ water, if you...
Change your water... you will Change your life...


Find out more about how you can fully detox simply by improving the quality of the water you drink. We do that personally via Electrolyzed Reduced Water (ERW) - Kangen Water.
#3 Detox - Terrain Detox Solution (Parasites)
So what is chlorine dioxide and how is it used?
Chlorine dioxide is a bio-cide. This means it kills all bacteria, viruses (which are really actually only natural detoxes) and fungus on contact through a process of oxidization. It has many applications from the food and beverage industry where it is used as an anti-microbial agent for washing foods and cleaning produce.
Chlorine dioxide is a gas and must be produced at the time of use. The most common and simple method for producing chlorine dioxide gas is a process of mixing sodium chlorite (NaCl02) and an acid activator. When these two substances are mixed, chlorine dioxide gas forms. The gas is a very simple and tiny molecule which contains one chlorine atom (Cl) & two oxygen atoms (O2)
It is extremely soluble so the gas can be dissolved entirely in water. Because of this property it can be used to safely and effectively purify water while completely deactivating viruses, bacteria, fungi and many types of small parasites.
Through 21 day protocols the life cycles of many parasites can be interrupted as well. This is critical as we all have parasites. Approximately 100+ years ago parasitology was replaced (suppressed) by the 'virology lie'. Viruses do not even exist. Refer our Terrain Paradigm teachings. Clean the terrain (including ridding it of parasites) and we can go a long way to restore the symbiotic balance we need to enjoy with nature.
It even neutralizes many toxins, pesticides, herbicides & pharmaceuticals that contaminate drinking water. Furthermore, it can do all of that without producing any harmful organic compounds as occurs with nearly all other disinfectants.


So, here's the solution. At no charge - it's our gift to you! We really want you to reclaim your health.
It's a simple three step process.
First, you ACKNOWLEDGE the emotion that's trapped inside you. After you have acknowledged it, then the second step is to FEEL the emotion. After you have felt the emotion, which might mean you have a cry, or scream, let off some steam, perhaps sleep, maybe take a few hours, or even days, to process/feel the emotion, then you must complete the third step - RELEASE the emotion.
NB: If the second step is taking months, years or decades, don't let the counsellor/therapist con you to think it takes that long. They are just making a living off your trapped emotion. It means they are not helping you take responsibility but instead enabling you.
This is the all too often incomplete step. A classic example is the person who never stops grieving a loved one. Or maybe never forgives somebody.
Only one person pays the price - YOU! For the sake of your health - process your emotions!
If you wish to see your emotions in your blood, refer to our page about Live & Dry Blood Analysis.
#5 Detox - The Elemental Code


If we look further into the symbiotic relationship we have with the planet we live on, then we begin to better understand and appreciate why it is vital we put our focused attention on these four elements.
Firstly, the SUN is vital for our wellness, as a key source of energy. Some of the healing and detox benefits of being outside in the sun as often as possible are:- boosts melatonin; increases serotonin; increased health; longevity of life; spiritual well-being; increase/expand/activate pineal gland; self confidence; boosts energy levels; promotes weight loss; better eyesight; enhanced vitality, bone health; strengthens immunity; mental focus; alertness; better mental health, to name a few.
When you integrate sun-gazing (around run-rise and sun-set when the UV index is zero) into the equation, this list is magnified tenfold.
Secondly, the AIR we breathe is just as important. And the way we breathe it plays a key role. Shallow breathing is a key contributor to stress, which affects the organs ability to rest or heal. Whereas, mindful, deep belly breathing / diaphragmatic breathing benefits include:- nervous system relax & re-set; building resilience to stress; changes your body's pH from acidic to alkaline state through oxidation; become more conscious; boosts your mood; improves concentration; lowers heart rate and blood pressure; removes stale air from the lungs; maximizes energy via lung capacity, etc, etc.
Did you know Ohm Chanting increases your nitric oxide production by nearly 1400%. This helps increase the flow of blood, oxygen and nutrients throughout the body, which can contribute to a longer life.
Thirdly, the WATER we drink is critically important. Since we have not been properly educated about the terrain paradigm, we need to improve our relationship with this element more than any other, hence why the water detox pathway is listed separately above.
Fourthly, EARTHING / GROUNDING is hugely beneficial too. One which we have been taught less about. It supercharges your electrons, giving you more free energy; reduces inflammation; reduces stress levels; improves blood pressure; helps fight oxidative stress; relieves muscle tension; normalizes blood viscosity; improves wound healing; improves circulation; assists digestion; improves respiration;; regulates hormonal rhythms; reduces inflammation; enhances bio-electrical processes throughout the body (more energy); improves sleep; reduces muscle pain; enhances immune responses; slows aging; prevents and calms chronic inflammatory and autoimmune diseases of all kinds.
Amazingly, all these benefits alone, when combined, can go a long way to restore your overall wellness entirely, at virtually zero cost. The only one of the four elements where we need to seriously consider the quality of what we are putting into our bodies, is the water we drink. And that's a massive part of the health equation that we talk about a lot in our seminars. Refer our page on Electrolyzed Reduced Water.






#6 Detox - Heart Brain Coherence




When your HEART and BRAIN are synchronized / coherent, then you can tap into the unified field.
It's the magical key that allows you to access your true healing potential.
Once you learn how to quieten the mind, and sit in your HEART CENTRE, you can find the answers to every thing, every single time. Yes! Every single time! Without fail! It's also known as 'being present', 'in the moment', 'the power of now', 'the seat of creation', 'the key to the universe' and 'the portal to the unified field'.
The healing potential of being in your HEART CENTRE is unbelievable - it can lead you to:- 1) a quiet mind; 2) clear vision; 3) a calm heart; 4) a soul that's lit; and 5) much easier decision making.
The greatest technique we teach in our seminars to help people manifest once they've quietened their mind (in this case detoxing/healing) from the field is the following:- If I knew the answer, what might it be? It's called possibility thinking, and all things can be created from this starting point. Once you train yourself to go within for the answers, over time, you become in tune with your body. Then you start to work with it instead of sabotage it. You unlearn what you've been falsely taught, get out of your own way, and access solutions from within. Yes, you actually discover that all the answers lay within!
Here's the catch - it takes time and discipline to learn how to do that!
Here's the beauty of it all, by design. Once you achieve HEART BRAIN COHERENCE your brain effectively says to your heart - it's okay, I've got your back. You can create now!
All it comes down to really, is how much can you learn to love (and trust) yourself!


#7 Detox - You are the Placebo


The true power of the PLACEBO is 'nothing has meaning till you give it meaning'.
This is an overlooked super power that we not only have access to, but can all harness, to select a new potential in the quantum field! The Placebo Effect represents a symbol of possibility.
How is this relevant to detoxing? This means we are able to control our own healing by thought alone. Whether you think you can heal/detox, or you can't, you are right either way.
Instead of putting your faith and belief in something exogenous outside of you, like a pill, medication or drug, simply select a new health potential in the quantum field.
It's really the actual thought that we accept, believe and surrender to! As a result we are able to re-program our autonomic nervous system to make the exact pharmacy of chemicals equal to any exogenous substance you might have previously chosen to ingest.
The real discussion to have is whether it's the inert placebo that's doing the healing or is it the body's innate capacity to heal by thought alone? Once you understand that you can get better, or heal, or detox, simply by combining a clear intention with an elevated emotion, you are actually changing your entire state of being.
Refer Dr Joe Dispenza's video short about 'YOU are the Placebo'.
This mindset, together with the possibility thinking technique mentioned above in '#6 Detox - Heart Brain Coherence' can help you to un-fire and un-wire so as to re-fire & re-wire. Now you well & truly own your wellness.
For things to change though, first we must change...

Unfortunately for many, that doesn't happen until the pain of staying the same becomes greater than the pain of change. We must ask ourselves, why do we ignore the tap on the shoulder when we know a mack truck is what follows next. If only we could learn from those before us who have been in similar situations.
#8 Detox - Paradigm Shift 1:- Germ to Terrain
This pathway is quite remarkable & can be as simple as it can be hard. Just like the witch doctor wields power over the tribe, so does the Germ Theory Lie propagated by the medical fraternity.
As we have shared elsewhere on this site, once you break this 100+ year old spell, passed down from your parents, and their parents alike, you are free to heal yourself. Whereas with the Germ Theory Lie, the label/diagnosis is the spell, but once you shift to the Terrain Paradigm, you now own your wellness destiny.
The most important thing to note, to motivate you to break the spell, is that your entire health position is totally relevant to the state/condition of your internal terrain. Just like the fish-tank analogy, because we are more than 75% water, once you clean your terrain, then you can totally restore your health back again.
This can be the most empowering thing you learn from this website - now, it's up to you how much you can fall in love with yourself again. SELF LOVE is to truly honour your body. It always comes back to SELF LOVE.
#9 Detox - Paradigm Shift 2:- Fear to Love








Theoretically, this is possibly the largest detox for the human condition. The fact people choose illness over wellness is because they live in fear. We address it from multiple angles. How it affects the MIND, the BODY and the SPIRIT.
We believe the real health pandemic today is the disconnect between the head and the heart. This is made possible through the disabling power of FEAR by the global marketing machine represented by the collusion of Governments, media and the pharmaceutical industry.
Between the prolific propagation of the Germ Theory Lie, and the spells cast by the medical fraternity (the medical labels are the spells) we find humanity are sadly choosing FEAR over LOVE by default. The majority of humanity are caught under the spell of their doctor, which sadly, is denying them their health and vitality.
Fear is totally dis-empowering and prevents people from raising their vibration high enough to escape this energy trap.
Fear shows up in the blood. Fear affects the acidity of the body/blood.
Fear impacts every decision/choice we make. Fear affects every relationship we have. Fear impacts our mental health. Fear makes every day so much harder to get through & can be totally crippling to the soul. When you think in terms of frequency, and you compare LOVE and FEAR, they are at different ends of the frequency spectrum as far as emotions are concerned.
If you allow your life to be ruled by fear you cannot attain good health or vitality. Fear increases your hydro-cortisol, which raises your inflammatory response and increases adrenaline which causes high blood pressure and increases your heart rate. Fear also causes shortness of breath and tightness in the chest (the result of flow stopping), nausea, vomiting and diarrhoea.
Fear also lowers your body's pH, which clumps your blood, stopping flow. Fear also gives you brain fog, affecting your cognitive function and your ability to think critically.
Love on the other hand has profound physical benefits, causes you to release oxytocin, which helps relax all your muscles, bringing you joy, which is the only thing that can balance your pH instantly. It also increases vitality and your immune health, sleep and appetite.
Love improves your brain circulation, mood and behaviour. Love also improves the flow throughout your whole body. Whether it's love for self, love for another, or even love for something you do passionately.
The ultimate act of self love is to put your health and well-being above everything else. After all, if we don't have good health, what do we have?
Love also increases the quality of relationships in your life.
Whereas the average person emits a fear-based frequency, someone who sends love and light energy to others emits an amazing love light frequency that is 5,000 times more powerful than the average human being.
When our bodies are infused with a loving and healing intent, our frequency and vibration increases to the point where you can literally change matter, heal disease and transform negative events.
DNA exposed to love has:- 1) a higher amplitude; 2) a shorter wavelength frequency; 3) more potential contact points.
The best way to upgrade your DNA is to choose LOVE over FEAR in all that you do, especially regarding your own health and wellness.
#10 Detox = Paradigm Shift 3:- Go Within Not Without






Interestingly, most people struggle to accept this truth!
Whilst the FEAR matrix in the detox discussed above was designed to cripple people, the SAVIOUR program is totally disempowering. It plays out in so many facets of our lives. Sadly, people are either oblivious to it, or in total denial, because their entire reality has been built around one or more of these identities.
There are the religious saviours who were put in place to indoctrinate and divide, therefore weaken the collective, and thus more easily control the masses.
Then there are the political saviours, who further divide and incite people against each other.
Now, in recent times, the latest saviour to take the prime position in society are the medical saviours, the doctors (via the white coat syndrome). By casting spells on people via the Germ Theory Lie they have been able to steal their health and vitality from them, whilst the majority don't have the resolve to break free from the spells. It is not until you are prepared to look at the root meaning, or etymology of doctor, which is to falsify, that you are able to see the truth.
The answers to everything lay within us.
By making humanity look outside for the answers, they are tricking them into disowning their own divinity. Instead of tapping into the unified field by going within, they have them waiting for someone else to rescue/save them from a reality they are not happy with.
Here's the hard fact - whilst you wait (for someone to save you), you cannot create!
#11 Detox - Mindset:- Thoughts/Words
Mind Hack #1 - I AM affirmations
We love to teach this to youth so they fully appreciate the power of these two words when used together. This is a magical manifestation key. Whatever follows these two words becomes your reality. So create mindfully. You can turn your entire life around by being more aware of your use of these two words.
For instance, instead of saying 'I am stupid', replace it with 'I am wise beyond my years because of my mindful choices', or perhaps change the thought 'I am not good enough', to 'I am a masterful creator and everything I focus on becomes my reality'. It all begins with the true power of 'I am......'
Mind Hack #2 - Omni Mantras
This tool is super powerful. It helps you to achieve laser-like focus all the time, enabling you to up-level your life in every way imaginable. It looks something like this:-
...... every day, in every way, with every breath and every step I take, I ...... (fill it in however you see fit). It is absolutely impossible for whatever it is you wish to focus on to not be in the forefront of your memory with this ever-present mantra.
Remember, we create everything twice. Once in our mind, then once in our external reality. The way you see yourself, through your 'I am affirmations', and making sure your mind is super focused with your 'everywhere mantras', you can realize your potential as a magnificent creative being.


Words are stored in our Cellular Memory
This is another thing you need to be aware of. The actual words we use will be stored in our own cellular memory. In fact, because we are more than 75% water, it goes even beyond that. The words we speak will impact our blood, because information is stored in water, and we were just reminded that we are more than 75% water. What that really means is that every cell in our body is listening to every thought and every word we speak. Choose wisely!
#12 Detox - Attitude of Gratitude:- The Fab 4


With the right ATTITUDE we can achieve anything!
Oftentimes, unfortunately, people sell themselves short. They give up on themselves. This formula was shared with Craig 30 years ago, early in his sales career, and it never let him down.
Study the sum of the corresponding numbers that make up the word. It's absolutely brilliant how they total the number 100.
The one guarantee in life is if you maintain a healthy ATTITUDE at all times, you can always make the most of every challenge.
What are the fab 4 and how are they related to ATTITUDE? Here's a framework that will enable you to keep a great ATTITUDE which contributes to an amazing mental health detox.
The fab 4 we refer to are:- Gratitude... Appreciation... Care.. Compassion...
Starting the day with an attitude of gratitude (programming your autonomic nervous system in advance) makes you a magnet to attract wonderful things and sets you up to have a day filled with appreciation for all things. By feeling gratitude before it takes place, the healing begins. It is the ultimate state of receiving emotionally, and you will accept, believe and surrender to the thoughts equal to that emotional state.
Just BEing mindfully grateful every day sets your energy/frequency at a high vibration so that you attract great opportunities throughout the course of the day. This creates a whole neural network that supports you attracting both positive experiences and positive people into your space/field.
Both this mindset and this heartset also enables you to be more caring to others across all of your inter-relationships, and therefore sets you up to show more compassion towards people, as you are being conditioned from within to mindfully consider others.

#13 Detox - Meditation, Intention, Prayer, Forgiveness (Broadcast/Amplify)
It's one thing to learn how to meditate properly, to be able to manifest your own expression of heaven on earth. Tapping into the unified field, creating from that field, by feeling real emotions, experiencing living in your future manifestation, and then bringing that future manifestation back into the present moment.
But when you create a mastermind group whilst meditating, via your deliberate, intentional, harmonious thoughts and vibrations, the power and amplitude of these thoughts are amplified/broadcast, forming a much greater creative force - as demonstrated by the HeartMath Institute and their Global Coherence Initiative
https://www.heartmath.org/gci/ as found in the video link to the side.


If you then take the manifestations from the meditation and multiply it by the intention of the group collective, learn how to apply the ancient Hawaiian prayer to this formula, which you can direct both inward and outward, the multiplying factor and benefits increase one hundred fold.
Not only can the Ho'opono'pono prayer self heal, it can also heal others at a distance through your own forgiveness. The key is if all of us were to take ownership for all that we perceive to fall short of creation, acknowledging the part that our own complacency played in this deficiency, only then can the collective fully heal and/or detox at an energetic level.
Imagine the healing and/or detoxing that would happen to the collective consciousness if we all took both responsibility for our own personal shortcomings and also owned our part in contributing to some of the injustices and imbalances across our entire planet today.
Then we would be in a position to harmoniously co-create the new heaven on earth we seek to experience.
For instance, if you were to apply the ancient prayer inwards, to your own body parts, or organs, or even at cellular level, through very specific, targeted intention, you can ask your body to forgive you for possible self harm, failure to honour self, poor decision making or lifestyle choices, and reinforce to self that you now acknowledge and honour your forgotten parts. Likewise, you can apply the same principles to somebody (whether you know them or not), or even to some thing (ie: the environment, nature, animals).
#14 Detox = The Big 3:- Eat, Sleep, Move (Diet, Sleep, Exercise)
Achieving balance in these three main areas of our life is essential, and one of the major keys to achieving holistic wellness. If you're putting all the essential nutrient dense foods into your body but not maintaining healthy sleeping patterns, or living a sedentary lifestyle with limited or no exercise/movement, then you cannot achieve optimum wellness and vitality.






Another way to super-charge your metabolism around a healthy nutrition intake is to practice intermittent fasting. When you combine mindful eating with mindful fasting, you are now consciously choosing wellness as a lifestyle choice.
Since the body needs more than 12 hours per day of no food consumption for cell regeneration to start to take place, intermittent fasting of at least 14 consecutive hours (or 16-18 hours for the more disciplined) every 24 hour period will mean you have at least two hours of cell regeneration where either apoptosis is able to happen, or autophagy takes place to complete the natural cell death cycle.
SLEEP
The all important sleep cycle is often under-estimated by the average person. It is vitally important to balance the circadian rhythm to support optimum health and vitality.
A circadian rhythm that's imbalanced, because of disrupted hormone production of melatonin and serotonin, can result in fatigue, gastrointestinal issues, changes in mood, amongst other physiological and mental health imbalances.
Apart from keeping the sleep environment dark, other extremely useful tools to help support a healthy sleep pattern are:- meditation; guided visualization; prayer and ancient solfeggio frequencies for things like relaxation, cell regeneration and even overcoming anxiety.
If you are attempting to correct irregular sleep patterns, in conjunction with cleaning up your diet, it's good to introduce exercise into your regime to assist balancing your energy levels. With all three working in harmony, you could adjust your sleep an hour or so at a time, until you fall into a healthier sleep pattern.

A beautiful example of ancient solfeggio frequencies
#15 Detox = Your Greatest Currency is Your Energy
By remembering that we are electro-magnetic beings, it makes sense that our greatest currency is our energy, or some say our frequency, or maybe even our vibration.
We love the radio station analogy. Imagine every one of us is a radio station. We each have our own frequency. And people are attracted to that frequency. Would people tune into your radio station? If so, what type of person would that be? Your vibe attracts your tribe!
We can raise our vibration by acting consciously. By, changing/raising our vibration we can attract more conscious beings into our lives. Ones who make better, heathier choices, more mindful practices, that make our life more meaningful. Who nurture our heart and soul along the way!
Whilst the mind is electric, our heart is magnetic, hence why we ATTRACT people into our space. Every human on the planet is 'linked to this magnetic field' and don't even need to be consciously aware of this to benefit from an increase in the collective consciousness.

The Gregg Braden video above is a powerful example of the magnetic fields of the earth spiking in direct proportion to the collective spike in the outpouring of human emotions. It dispels the basis of modern day science (for the past 300 years) being built upon the myth of two false assumptions:- 1) that everything is separate from everything else, and 2) that our inner experience, our thoughts, feelings, emotions and beliefs have no effect on the world outside of our bodies.








#16 Detox = Transitioning from Isolation to Connectivity to Collaboration
Loneliness leads to depression. Isolation leads to depression. Isolation is a form of pain and suffering often interwoven with trauma of abandonment. People need human contact. They need people they can confide in.
Human desire for connection versus the fear of isolation
Human contact and human connection is everything. We need to physically see and touch other humans. Serotonin and oxytocin get released when we are in contact with other people. We are social creatures, we are not designed to remain isolated.
If you are not spending enough time with other humans (social isolation) the result will culminate with your body releasing a molecule called tachykinin, referred to as the loneliness molecule, which makes us more fearful, paranoid and impairs our immune system. It is a punishment molecule which our body produces that informs us we are not spending enough time connecting with people whom we trust.
The psychological and physical health benefits of social contact can actually boost life expectancy.
#17 Detox = Pineal Gland Activation (De-calcification)




Refer Dr Joe Dispenza - the role of brainwaves in meditation
Why is the Pineal Gland, often referred to as the Third Eye because it is the doorway to profound visions, so significant to our general well-being (homeostasis), and what really happens when we decode the mystical science behind the activation of it?
When you learn how to activate the pineal gland, the visions that you have are not 'visualizing' but rather 'profound visions', meaning it's actually happening to you! Think of it as the brain's radio receiver.
Once you learn how to take your attention off everything material (three dimensional reality), a narrow focus on matter, and you begin to broaden your focus, and create what's called a divergent focus, when you do that properly, the act of opening your awareness and putting your attention on nothing, begins to suppress the thinking brain (the limbic brain), and slows brainwaves down into very organised coherent alpha. Once you silence the activity in the neo-cortex you get beyond the analytical brain, the thinking brain.
By changing our brainwaves from beta to alpha, and then continue through to theta, we are able to bypass the analytical mind in order to enter the body’s operating system - otherwise known as the autonomic nervous system or the subconscious mind. Measuring in at approximately the size of an apricot and located midbrain, directly under the neocortex (the thinking brain), exists the limbic brain, which is the seat of the autonomic nervous system. When we can consciously enter the midbrain by slowing down our thinking and changing our brainwaves, we can begin to influence - program/reprogram - our body in very specific ways.
As your nervous system becomes electrically activated, the amplitudes of energy go up in the brain, resulting in a profound firing & then you make that amazing chemical called DMT (dimethyltryptamine). Now it releases updated versions of Melatonin, the strongest antioxidant known to man (anti-cancer, anti-aging, anti-heart disease, anti-neuro-degenerative, anti-inflammatory, anti-microbial anti-stroke). Now you no longer move through space to experience times, but rather, you move through times, and you experience dimensions or spaces.
The biggest lie you have ever been told is that you are a lineal being living a linear life - you are actually a dimensional being living a dimensional life.
Activating your pineal gland produces high frequency emotions such as ecstasy, bliss and joy, which can balance your pH in your blood instantly.
Fluoride (in your toothpaste & water) create neuro-toxicity which impairs your vivid, lucid, profound life changing dreams. Remember, at the same time, by no longer putting our attention on matter, but instead on energy or frequency, we enter the quantum field. We become pure consciousness and we can create reality as more energy and less matter. And we can execute greater effects on the world of 3D matter.
Some very simple and super effective ways that you can decalcify your pineal gland are:- 1) filter your water; 2) change your toothpaste; 3) grow your own foods or; 4) eat certified organic foods (not highly processed).
We highly recommend you become a student of Pineal Gland Activation for your autonomic nervous system benefits alone, not to mention the benefits that come from learning how to create from the quantum field.
#18 Detox = Black Mold (Internal/Food & External/Environment)
When the words CITRIC ACID appear on a food label, many believe it comes from limes and lemons. The truth is that citric acid is in fact poison & comes from genetically modified black mold. It is not by accident!
Citric acid is naturally found in citrus fruits, but synthetic versions, which are produced from a type of mold, are commonly added to foods that can be found in almost every item on the market shelf, from snacks, candy, and dairy foods to sauces, seasonings, canned foods as well as medicines and supplements, particularly those that are citrate-based. Many times it is used in home canning as a preservative. It can also be found in cosmetics, cleaning products, and laundry soap.

#19 Detox = Electro-Magnetic Radiation (The Field Cleanse)
The home environment is vital for our health and well-being, but most houses are saturated with dangerous levels of electromagnetic radiation?
Thousands of studies link low-level wireless radio frequency radiation exposures to a long list of adverse biological effects, including:- DNA single & double strand breaks; oxidative damage; disruption of cell metabolism; increased blood-brain barrier permeability; melatonin reduction; disruption to brain glucose metabolism; generation of stress proteins, plus many more.
#20 Detox = Focus - Where Your Attention Goes Your Energy Flows
Change your focus change your life!
Think of your life as one giant canvas, and you are painting your masterpiece. Your ability to focus will greatly enhance your creative expression.
If what you focus on expands and grows, then the thoughts you have every day, and then act on, are what determines where your energy is going.
If you focus on the pain, you suffer. Whereas if you focus on the lessons, you grow. Same experiences, just a healthier attitude and mindset that will help you upgrade your DNA with every related thought.


#21 Detox = Paradigm Shift 4:- The Duality Lie vs Being Heart Centred
Yes, it's true, we live in the 3D matrix. Our daily experience constantly tells us our minds work independently and in advance of our bodies. Every waking moment, we make decisions that precede our actions. It seems that our bodies are controlled by our thoughts. More importantly, it's our programming that determines over 95% of our thoughts, decisions and actions daily.
But we are constantly told we cannot escape this matrix - that duality is our only reality, and our choices only exist in this plane/dimension. But that's not exactly true.
Whilst we focus on the duality lie, that's all we will ever see. So, in a way, the lie becomes our truth as we don't ever look outside of that lie. It's by design! To keep us trapped.
Why is that so? To disempower us. To have us believe our choices only exist between light and dark, above and below, good and bad, right and wrong, etc, etc......
#22 Detox = Paradigm Shift 5:- Stop Waiting Start Creating
If you really want to free your mind - this is a powerful detox too.
Take back control of your life, and your future. Every other person we meet is waiting for somebody to step up and save them. This is so devastatingly disempowering. You must be the master of your own destiny.
If you are not steering your own ship then you cannot complain if it's off course.
But even worse, if you hand over all control to another person or entity (eg: politician, religion, doctor), then you do not have autonomy over your own sovereignty. Especially concerning your own wellness.
There is only one way to CREATE A LIFE BY DESIGN......
STOP WAITING FOR SOMEBODY ELSE TO FIX YOU OR FIX YOUR LIFE.
There are so many saviour programs running across the planet today. The latest to rise to the very top is the WHITE COAT SYNDROME. The new world religion is actually PHARMAKEIA.
People cannot identify with wellness any more, they need to run to their doctor to tell them what to take to stay alive. It is an addiction that has spread like wildfires across the planet thanks to the medical lies over the past four years. If you think wellness comes in the shape of a tablet, pill, drug or medication you are under the spell of PHARMAKEIA too.
This is why most people have no idea how to create health and wellness for themselves. How to maintain vitality. Very few are even aware they can upgrade their own DNA.
Once again this is a fear based program running from your subconscious mind. In order to break the spell, you need to quieten your mind, sit in your HEART CENTRE, and start creating a life full of vitality.
For things to change, first we must change......
#23 Detox = Paradigm Shift 6:- Let Go Of The Anger


#24 Detox = Paradigm Shift 7:- Take Responsibility
Did you know your language patterns can reveal whether you are taking responsibility in your life?
What does that mean?
If you look closely at the model to the left, this is a classic depiction of the 'game of life' taking place. What you are looking at is the game that takes place BELOW THE LINE OF RESPONSIBILITY.
We are going to show you how to break free from this game.
#25 Detox = Paradigm Shift 8:- Let Go Of The Ego
Over time, the EGO has been expressed in the conscious awareness domain in 100's of different ways. From separateness to ignorance, pride, jealousy, power, judgmental, materialistic, self important, complaining, and many, many more.
You notice one thing all of these have in common - they are low vibrational.
What is helpful to understand, is that ego, just like judgment, along with self righteousness, all come from being off-centred (the direct result of living the duality lie, as explained in detox #21). It's the difference between being stuck in the mind versus BEing Heart Centred.
When you are stuck in your head, you are operating from your pre-existing programming, actually moving between the past and the future, always busy, always feeding/fueling your ego-centric expression of self. Living purely from the 3D duality matrix. In service to self instead of to the world.
The reason we teach techniques to help people move from the head to the heart is to free them from the self-centred egoic paradigm, to one where they can connect to the unified field. Where they can recognize and accept their oneness with the universe and are able to manifest from the 'present moment'.
You have to collapse the ego to truly manifest from the present moment,


#26 Detox = Paradigm Shift 9:- Be, Do, Have not Have, Do, Be


#27 Detox = Live A Purpose Driven Life






























































































































































